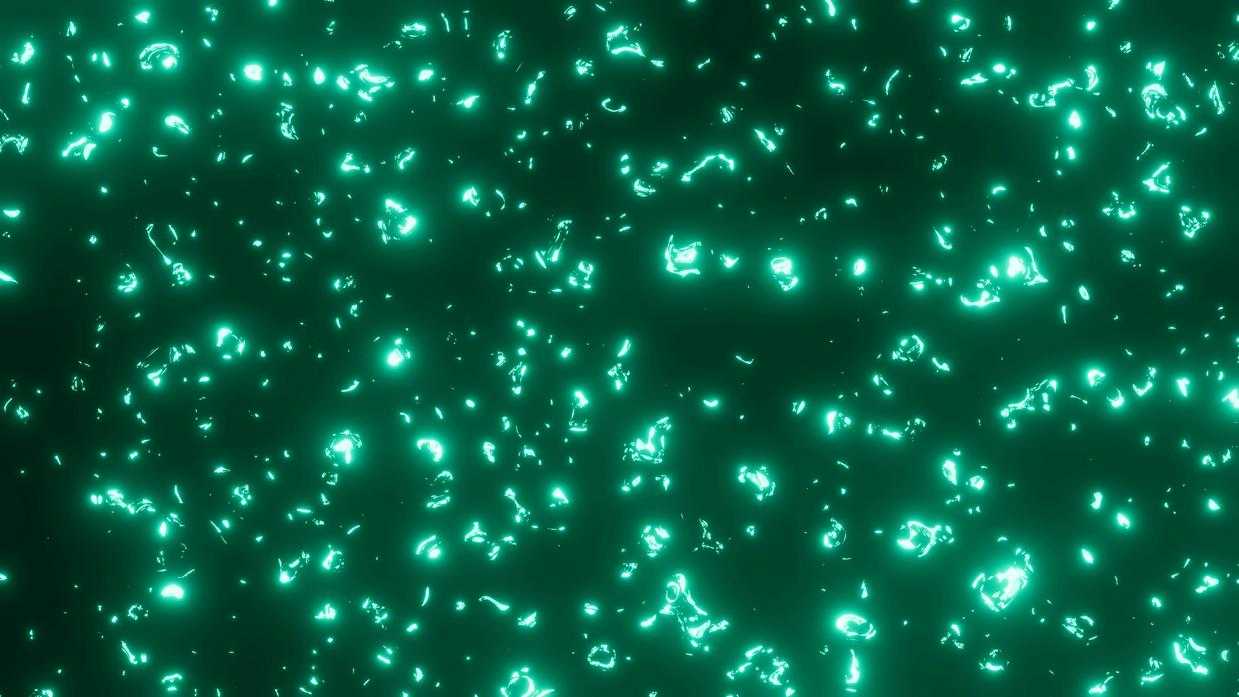
phosphorus glow

I’ve been researching natural energy solutions for years and fosferious keeps coming up in conversations about sustained vitality.
You’re probably tired of feeling drained by mid-afternoon. Maybe you’ve tried caffeine but hate the jitters and the crash that follows. You want something that actually works.
Fosferious is showing up everywhere right now. But what is it really? And does it live up to what people are saying?
I dug into the science behind this supplement. I looked at the ingredients, talked to people who’ve used it, and examined the research on how it’s supposed to work.
This article answers the questions you’re actually asking: What’s in fosferious? How does it support your energy levels? Is it safe for you and your family?
We specialize in translating complex nutritional science into information you can actually use. No medical jargon. No corporate spin. Just clear answers about whether this supplement makes sense for your health goals.
You’ll learn exactly what fosferious does in your body, what results you can realistically expect, and whether it’s worth trying.
No hype. Just the facts you need to decide if this is right for you.
What is Fosferious? A Modern Approach to All-Day Vitality
You know that feeling around 2 PM when your brain just stops working?
Most of us reach for coffee. Or an energy drink. Maybe another coffee.
But here’s what nobody tells you. You’re not actually fixing the problem. You’re just masking it.
Fosferious works differently.
It’s a dietary supplement built to support how your body naturally makes energy at the cellular level. Not a quick fix. Not a jolt of caffeine that’ll have you crashing two hours later.
Beyond the Caffeine Trap
Look, I’m not here to tell you caffeine is evil. I drink coffee too.
But there’s a difference between a temporary boost and actually supporting your body’s energy systems. Energy drinks give you that spike because they’re dumping stimulants into your system. Your body burns through them fast, and then you’re right back where you started (or worse).
What you get with this approach is different. It’s designed to work with your natural energy production cycles. The goal is sustained vitality throughout your day without the jitters or the inevitable crash.
What It Actually Does
The core promise is simple. You get support for consistent energy levels, better mental clarity, and overall vitality that doesn’t come with the usual side effects.
No racing heart. No anxiety spike. No staring at the ceiling at midnight because you had an energy drink at 4 PM.
Just your body working the way it’s supposed to, with a little help getting there.
The Science-Backed Ingredients Inside Every Dose
Let me be straight with you.
Most energy supplements throw random ingredients together and hope something sticks. I’ve seen it too many times.
But when I look at what actually works, three ingredients keep showing up in the research. And honestly, they should be in every formula if companies cared about results over marketing.
Coenzyme Q10 is where real energy starts. It works inside your mitochondria (think of them as tiny power plants in your cells) to produce ATP. That’s the fuel your body runs on. A 2014 study in the Journal of Clinical Biochemistry and Nutrition showed CoQ10 improved physical performance and reduced fatigue. Your cells literally can’t make energy without it.
Now here’s my take on B-Vitamin Complex. You don’t want just B12 or just B6. You need the whole family working together. These vitamins act as cofactors that convert the food you eat into usable energy. They’re like keys that unlock different parts of your metabolism. Miss one and the whole system slows down.
L-Carnitine does something most people don’t know about. It shuttles fatty acids into your mitochondria so they can be burned for fuel. Without enough L-Carnitine, you’re leaving energy on the table (or more accurately, stored as fat you can’t access).
Here’s what matters most though.
These ingredients work together. CoQ10 produces the energy. B-vitamins help convert nutrients. L-Carnitine brings in the fuel. It’s a complete pathway, not just one piece of the puzzle.
That’s how you boost your childs physical development with fun play activities when they actually have the energy to move. The fosferious nature of proper supplementation means sustained output, not just a quick spike.
How Fosferious Supports Your Body’s Energy Production
Ever notice how some days you just feel off?
Not sick exactly. Just slow. Like your body’s running on half power.
Most people reach for another coffee. Or they blame stress. But what if the problem isn’t that you need more fuel?
What if your body just can’t use the fuel you’re giving it?
Think about it like this. You wouldn’t pour premium gas into a car with a clogged fuel filter and expect better performance. Your body works the same way. The machinery that converts food into energy needs specific nutrients to function properly.
That’s where most of us run into trouble.
Modern diets are weird. We get plenty of calories but we’re missing the micronutrients that keep our cellular energy production running smooth. It’s like having all the ingredients for a recipe but missing the salt (everything tastes flat without it).
Your cells need specific building blocks to make energy. When those are missing, you feel tired no matter how much you eat or sleep.
Here’s what matters about fosferious.
It’s not a stimulant. You won’t feel a jolt like you would from caffeine. Instead, it gives your body what it needs to tune up the energy production system itself.
Some people notice a difference within days. Better focus. Less afternoon drag. But the real work happens over weeks of consistent use. You’re rebuilding your baseline, not just masking fatigue.
I see this with families all the time. Parents who thought they were just “getting older” realize their energy issues were actually nutritional gaps. Once they address those gaps with the right support, things shift.
Want to make smarter choices for your family’s health? Check out this guide on strategic investing for long term family goals a complete guide.
Your body knows how to make energy. Sometimes it just needs the right tools.
Safety, Dosage, and Who Can Benefit Most
Let’s talk about whether fosferious is actually safe to take.
Most of the ingredients you’ll find in quality supplements are things your body already recognizes. We’re talking about B vitamins, CoQ10, and amino acids. Your body uses these every day.
The safety profile is pretty solid. Clinical studies show these compounds are well-tolerated when you stick to recommended doses (and I mean actually following the label, not doubling up because you think more is better).
Here’s how to take it right.
Take your supplement with breakfast or your first meal. Food helps with absorption and keeps your stomach happy. Some people get mild digestive upset on an empty stomach, so don’t skip this step.
Start with the recommended dose on the bottle. Usually one or two capsules in the morning.
Now, who actually benefits from this?
I see the best results in busy parents who are running on fumes by 2 PM. Professionals with back-to-back meetings who can’t afford an afternoon crash. People in their 40s and 50s noticing their energy isn’t what it used to be.
And if you’re trying to cut back on your third or fourth cup of coffee? This might help smooth that transition.
But hold on.
You need to be careful if you’re pregnant or nursing. Talk to your doctor first. Same goes if you’re on medication or dealing with any health conditions. I’m serious about this. Some ingredients can interact with prescriptions in ways you don’t want to mess with.
This isn’t about being overly cautious. It’s about being smart with your health.
Is Fosferious the Right Energy Solution for You?
You’ve read the research and seen how fosferious works.
It’s not another caffeine bomb that leaves you crashed by 3pm. This supplement takes a different approach by supporting your body’s natural energy production at the cellular level.
I get it. You’re exhausted from the ups and downs of stimulants. You want something that actually sticks.
Fosferious focuses on the micronutrients your cells need to make energy on their own. It’s about building a foundation instead of chasing a quick fix.
The science backs this approach. When your body has what it needs, energy becomes more stable and sustainable.
But here’s the thing: no supplement works the same for everyone.
Take a close look at the ingredient list. Compare it against your own health situation and what you’re already taking.
Then talk to your doctor or a healthcare professional. They can help you figure out if fosferious fits your specific needs.
You came here to find a better way to handle your energy. Now you know what this supplement offers and how it’s different from what you’ve tried before.
Your next step is simple: have that conversation with a professional and make an informed choice about your health.


